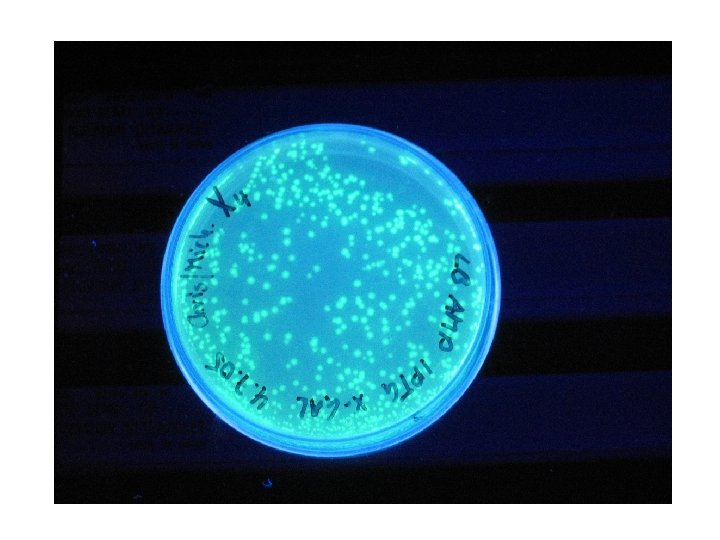

Green Fluorescent Protein GFP Das GFP ist ein

- Slides: 15
Green Fluorescent Protein (GFP) • Das GFP ist ein Protein von 238 Aminosäuren ursprünglich aus der Qualle Aequoria victoria isoliert. • Diese erzeugt grüne Biolumineszenz. • Das Protein kann in jedem Organismus ohne zusätzliche Cofaktoren exprimiert werden.
Anwendungen von GFP • In vivo Verfolgung von Proteinen • Aufzeichnung von Gen Expressionen • Beobachtung von Zellpopulationen bzw. Differenzzierung • Studium von Infektionen
Struktur des GFP • Die Struktur von GFP zeigt eine Form die an eine Kanne erinnert. Sie wird als “β-Can” bezeichnet • Dies besteht aus 11 βFaltblättern und einer zentralen α-Helix
Fluorophor • Fluorescenz wird durch einen Fluorophor erzeugt welcher im Zentrum des Proteins sitzt.
Die Struktur des Fluorophors • Der Fluorophor entsteht in einem Tripeptide -Ser 65 -Tyr 66 -Gly 67 • Dessen Bildung geschieht autokatalytisch
Mechanismus der Fluorophor-Bildung Durch Ringbildung entsteht ein konjugiertes aromatisches System.
Was ist Fluorescenz? • Ein Molecül absorbiert ein Photon und hebt es auf eine höhere Schale (Energielevel). • Nach 10 -9 to 10 -4 Sekunden fällt das Elektron auf die Ausgangsschale (Energielevel) zurück und emittiert ein Photon. • Das emittierte Photon hat eine geringere Energie (größere Wellenlänge) als das absorbierte. • Konjugierte und aromatische Syteme zeigen oft Fluorescenz
Spektrale Charakteristik des wild-Typ GFP • Anregungsmaximum bei 395 nm (UV) mit einem kleinen peak bei 475 nm (blau) • Emission bei 508 nm (grün) • Quantenausbeute zwischen 0. 72 to 0. 85
Bedeutung von Wasserstoffbrücken zur Fixierung des Moleküls • Der isolierte Fluorophor fluoresziert nicht. • H-Brücken zu nahegelegenen Seitenresten erzeugen erst Fluorescenz
Mutationen führen zu blauen und roten fluoresierenden Proteinen • • Ser 65 nach Thr Phe 64 nach Leu Tyr 66 nach His Tyr 145 nach Phe